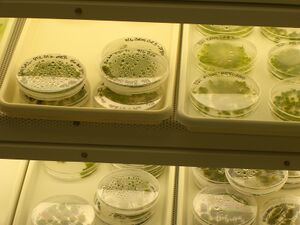

Physcomitrella patens
From OpenWetWare
(Redirected from Moss)

References
- PhyscoBase
- Luciferase expressed
- dsRed expressed
- this book has a chapter on moss molecular biology
- I started adding citations to citulike with the tag 'physcomitrella'
- p.s. isn't there a better way to share fulltext pdfs of articles, or just citations, at least, on OWW? If not, lets just make a new citulike account and share the login Mac Cowell
Links
- http://biology4.wustl.edu/moss - good protocols here (methods tab)
- http://moss.nibb.ac.jp
- http://www.biologie.fu-berlin.de/
- http://www.cosmoss.org
- http://www.plant-biotech.net
Protocols
Moss is cool